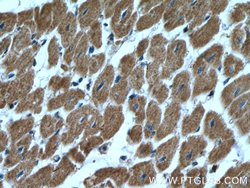
Prohibitin 2 Rabbit anti-Human, Mouse, Polyclonal, Proteintech 20 &mu;L;

missing translation for 'onlineSavingsMsg'
Learn More
Learn More
Prohibitin 2 Rabbit anti-Human, Mouse, Polyclonal, Proteintech
Rabbit Polyclonal Antibody
Brand: Proteintech 12295-1-AP-20UL
This item is not returnable.
View return policy
Description
PHB2 acts as a mediator of transcriptional repression by nuclear hormone receptors via recruitment of histone deacetylases. This protein functions as an estrogen receptor (ER)-selective coregulator that potentiates the inhibitory activities of antiestrogens and represses the activity of estrogens. It competes with NCOA1 for modulation of ER transcriptional activity. It is probably involved in regulating mitochondrial respiration activity and in aging.Specifications
| Prohibitin 2 | |
| Polyclonal | |
| Unconjugated | |
| PHB2 | |
| BAP, Bap37, D prohibitin, p22, PHB2, PNAS 141, prohibitin 2, REA | |
| Rabbit | |
| Antigen Affinity Chromatography | |
| RUO | |
| 11331, 12034 | |
| -20°C | |
| Liquid |
| Immunocytochemistry, Immunoprecipitation, Western Blot, Immunofluorescence, Immunohistochemistry (Paraffin) | |
| 0.4 mg/mL | |
| PBS with 50% glycerol and 0.1% sodium azide; pH 7.3 | |
| O35129, Q99623 | |
| PHB2 | |
| Prohibitin 2 Fusion Protein Ag2977 | |
| 20 μL | |
| Primary | |
| Mouse, Human | |
| Antibody | |
| IgG |
Product Content Correction
Your input is important to us. Please complete this form to provide feedback related to the content on this product.
Product Title
Spot an opportunity for improvement?Share a Content Correction